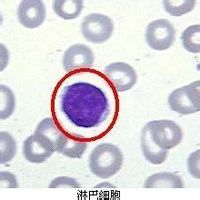
溢出性蛋白尿 溢出性蛋白尿

溢出性蛋白尿:腎小球濾過及腎小管重吸收均正常,但由於血中異常蛋白質增多,經腎小球濾出,超過腎小管重吸收能力,在尿中出現而產生的蛋白尿稱為溢出性蛋白尿。如(溶血性貧血)血紅蛋白尿,肌紅蛋白尿,多發性骨髓瘤患者排出的輕鏈尿等。 RNX
相關詞條
-
無症狀性蛋白尿
"無症狀性蛋白尿(Asymptomatic 腦震盪、冷水浴後出現的蛋白尿
無症狀性蛋白尿 無症狀性蛋白尿原因 無症狀性蛋白尿分類 無症狀性蛋白尿分類常見的情形 -
蛋白尿
由於腎小球濾過膜的濾過作用和腎小管的重吸收作用,健康人尿中蛋白質(多指分子量較小的蛋白質)的含量很少(每日排出量小於150 mg),蛋白質定性檢查時,呈...
疾病概述 疾病預後 病症病因 疾病檢查 相互鑑別 -
腎小管蛋白尿
系腎小球濾過膜正常,但原尿中正常濾過的蛋白質不能被腎小管充分回吸收所致。
概述: 尿蛋白正常值: 分型說明: 小兒時期蛋白尿的常見病因: 單純性蛋白尿: -
病理性蛋白尿
病理性蛋白尿是腎臟疾病的可靠指標,是指蛋白尿持續超過0.15g/d。
(一)基本介紹 (二)基本分類 -
小兒腎性糖尿
小兒腎性糖尿是指在血糖濃度正常或低於正常腎糖閾的情況下而出現糖尿,患者空腹血糖及糖耐量均正常。
概述 流行病學 病因 發病機制 臨床表現 -
小兒腎性胺基酸尿症
小兒腎性胺基酸尿症所屬疾病之一,以尿中排出過多胺基酸為特徵的健康搜尋一類代謝疾病,可分為腎前性、腎性及混合性。
概述 流行病學 病因 發病機制 實驗室檢查 -
腎病綜合徵
蛋白從尿中丟失而引起的一種臨床綜合徵。主要特徵是;大量蛋白尿、低蛋白血症、嚴重水腫和高膽固醇血症。泌尿系統解剖圖腎病綜合徵是以大量蛋白尿、高脂血症...概括因多種腎臟病理損害所致的嚴重蛋白尿及其相應的一組臨床表現,因表現...
簡介 病因分類 病理特徵 腎病綜合徵的中醫辨證 臨床表現 -
尿蛋白陽性
、腎臟澱粉樣變性等。病理性尿蛋白除了腎小球性蛋白尿外,還有腎小管性蛋白尿、溢出性蛋白尿、腎組織性蛋白尿。腎小管性蛋白尿是由於在病理狀態下,腎小管重吸收蛋白的功能障礙引起的,多見於腎小管及間質的疾病。溢出性蛋白尿是由於...
病理 表示方法 臨床意義 陽性原因 腎病類型